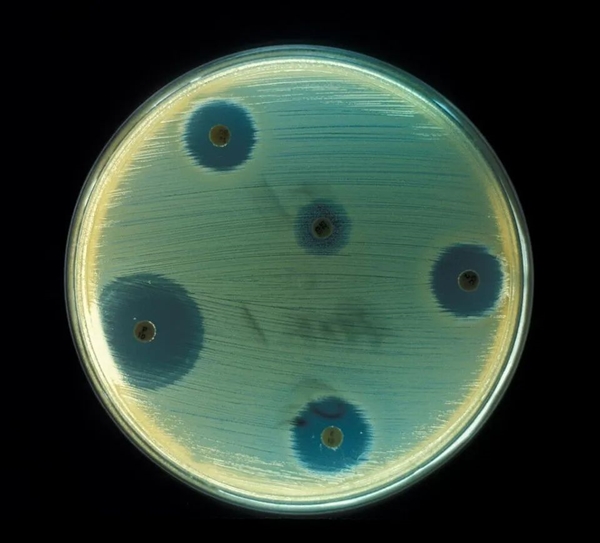
S1910e405-0dfb-4b72-912c-81de67636b84

尽管人类知道细菌存在的历史并不久远,而真正了解细菌感染是1900年前后了,但是人类系统性使用“抗生素”的历史至少有几千年了。
无论西方还是中方,古代的医学典籍都会记录一些对特定疾病有效的药材,而其中一些就是因为药材中包含了对相应细菌有效的抗生素,最常见的古代“抗生素”是一些霉菌和植物提取物。

图:青霉菌,青霉素来自它
只是古代的人们并不清楚这些疾病(感染)是细菌引起的,也并不清楚是在用抗生素对抗细菌,只是他们正巧发现了这种疾病可以用这种物质治疗,并记录了下来而已。
人类真正意义上的第一种抗生素是1909年出现的,当时德国医生保罗·埃利希 (Paul Ehrlich) 发现了一种叫做砷凡纳明的化学物质,它可以有效治疗梅毒。
之所以说这是第一种抗生素,是因为当时的保罗·埃利希已经有了抗生素的概念了,就是找到特定化学物质,它对病原体细菌细胞有效,而对其它细胞无效。
现在流传的故事是,保罗·埃利希发现某些化学染料会使某些细菌细胞着色,但不会使其他细菌细胞着色,所以他坚信存在某种化学物质只对特定细菌有效,而不会伤害正常细胞。

自从抗生素诞生以来,人们就发现,细菌对抗生素的耐药性是越来越强了,所以你经常会看到“抗生素滥用”、“抗生素制造超级细菌”之类的报道。
不过,我现在要告诉你的是,抗生素对抗细菌的时代可能还有一个问题,就是当一个细菌完全适应某种抗生素,以至于我们无法用已有抗生素对抗它时,下一种抗生素可能也会不起作用。
至于为什么会是这样,就要回答一个困扰人们一个多世纪,甚至直到今天都有争议的问题:细菌的变异是随机的还是有目的的?
或者说,细菌是先遇到抗生素后才会产生抗药性,还是说在没有遇到抗生素之前,也会产生抗药性?
有一个简单的实验可以解释这个问题,细菌抗药性可能不需要遇到抗生素也会产生,而且现在越来越的实验证实了这点。
1943 年,两个科学家——萨尔瓦多·卢里亚 (Salvador Luria)马克斯·德尔布吕克 (Max Delbrück)发明了这个实验。

图:噬菌体模型
这个实验是怎么回事?
到底是噬菌体的存在才让细菌产生相应噬菌体抗体,还是说噬菌体抗体只是细菌随机突变的一个幸运结果,上个世纪这个问题存在巨大的争议。
为了解决这个争议,卢里亚和德尔布吕克开始合作,但是经过几个月的实验,他们都没有成功。
据信,1943年1月16 日晚上,卢里亚从一位同事在老虎机上赢得大奖而得到灵感(估计得奖的那哥们很兴奋逢人就说),才设计了这个经典实验。
卢里亚找来一些试管和培养皿,每个试管里都装满了适合大肠杆菌繁殖的营养肉汤,而每个培养皿里都装有噬菌体。
然后他将大肠杆菌放入试管中培养,让它在里面自由繁殖,很快细菌浓度就飙升,并导致每个试管都变得浑浊(一天之后)。

图:噬菌体攻击细菌
然后,卢里亚将每个试管中的大肠杆菌转移到那些充满噬菌体的培养皿中,并在一天之后,计算每个培养皿中耐药细菌菌落的数量。
上述争议的两个观点会产生两种不同结果,并体现在耐药细菌菌落的数量上。
第一种:
如果细菌只通过与噬菌体相互作用来产生抗性,那么试管中的细菌将不会有抗噬菌体的变种;
另一方面,当这些细菌被转移到含有噬菌体的培养皿中时,只有少数细菌会产生耐药变种,之后每一种抗噬菌体的变种都会生长成一个菌落,但剩下的细菌会死于感染。
其实,这种情况甚至都可以观察出来,那就是所有细菌转移到培养皿中之后,它都会先经历变得清澈(因为细菌减少),然后再开始变得浑浊,它们变清澈的情况会一样,只是变浑浊的情况会不太一样,因为每个样本的抗性何时出现不确定。
第二种:
如果细菌不是与噬菌体相互作用来产生抗性,那么试管中的一些细菌已经是抗噬菌体的变种。

早期出现抗性突变(红色)将产生大量变体个体,而后期则很少?Qi Zheng
在这种情况下,如果开始的第一代细菌就是变异的抗性变种,那么当它转移到培养皿中时,至少有一半的细菌会在后代中产生抗性。如果在第二代中发生变异,那么至少八分之一的细菌产生抗性,以此类推。
如果你不太理解前面的数据,只要了解,在这种情况下,晚期突变发生得更频繁(因为细菌数量大),但产生的抗性变异却更少,而早期突变很少发生(因为细菌数量少),但会产生大量的具有抗性的变异个体。
这个和老虎机的得奖情况很像,小额奖金面额小但频繁,而大额奖金金额大但很少发生,卢里亚估计就是这样得到灵感的。

大肠杆菌转移到培养皿之后的情况@Qi Zheng
卢里亚最后统计的结果是第二种,(第二天)大多数培养皿中没有或只有少量的抗噬菌体菌落,但有几个培养皿中含有大量的抗噬菌体菌落——最初几代就获得抗性。
这意味着一些细菌样本在与培养皿中的噬菌体相互作用之前,就已经产生了抗噬菌体菌落,所以并不是噬菌体导致了抗性的发生。
你可能已经发现了,我们这里好像只提到卢里亚,说好的两人合作呢。
其实,实验完成后,卢里亚给德尔布吕克发了一张纸条,要求他检查自己的工作,不过后面两人共同完成了论文,描述了实验方案和测量细菌突变率的理论框架。
我们现在看起来这个实验很简单,但其实它至今都具有现实意义,因为它意味着细菌可以对尚未开发出来的抗生素产生耐药性,他们两人也因此获得了1969年的诺贝尔生理学或医学奖。
之后,其他科学家也用相似的方法,用青霉素和结核病药物代替噬菌体,实验结果也是一样的,一些样本可以在完全没有接触过这些抗生素的情况下天生具有抗性。
所以,不要觉得抗生素永远可靠,如果现在常用的抗生素已经不再有用,那么新的抗生素出现,也不意味着它对所有人都有效。






















































